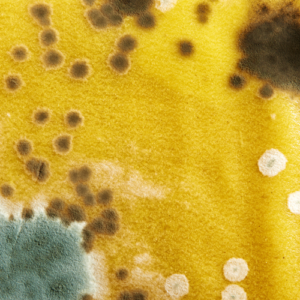

And When to Call a Professional
In Upstate South Carolina, mold problems are especially common due to the region’s humid climate and seasonal rainfall. Homes in areas like Greenville, Spartanburg, and Anderson are more prone to mold growth in basements, crawl spaces, and HVAC systems. According to national housing data, approximately 70% of U.S. homes have some form of mold, and 28% of people are genetically predisposed to mold-related illness. Understanding the risks of mold toxicity in this part of the country is crucial for protecting your family’s health and your home.
Many homeowners don’t realize that symptoms like fatigue, brain fog, and sinus trouble may not be random—they could be signs of mold toxicity. Mold exposure can lead to chronic health problems when spores or mycotoxins are inhaled over time, especially in homes with poor ventilation, hidden leaks, or recent water damage.
Toxic mold in the home can lead to serious symptoms and long-term exposure risks, especially when left untreated. Knowing the early symptoms of mold exposure can help you act quickly.
If you’re feeling constantly drained, even after a full night’s sleep, mold exposure might be to blame. Mycotoxins can interfere with your body’s energy systems.
Difficulty concentrating, forgetfulness, and slow thinking are common among those living in mold-infested environments.
Chronic congestion, sneezing, or post-nasal drip can indicate your respiratory system is reacting to mold spores.
Mold exposure has been linked to migraines and tension headaches, especially when you spend long periods indoors.
Redness, itching, or hives without a known allergy may be your body’s reaction to mold toxins.
Burning or watery eyes, scratchy throat, and dry coughs often develop from prolonged mold exposure.
Some people report depression, mood swings, or anxiety after living in moldy environments—likely due to nervous system inflammation.
Getting sick more often than usual? Mold weakens your immune system and can contribute to infections like bronchitis or pneumonia.
Mold toxicity has been linked to inflammation, which can cause discomfort in joints or muscles without any physical strain.
If symptoms improve when you’re on vacation or at work, but worsen at home, your environment could be the problem.

Not all mold is visible. Be on the lookout for:
Mold thrives in dark, humid areas. Even a small leak can trigger serious growth behind walls or under flooring.
Preventing mold from taking hold in your home is one of the best ways to protect your health and avoid costly remediation. Here are a few practical steps:
Proactive moisture control and ventilation go a long way toward keeping mold out and maintaining healthy indoor air.
If you recognize these signs of mold toxicity, don’t wait. Mold spreads quickly and can make health problems worse over time.
Here’s what to do:
At Rehab Restoration, we offer thorough inspections and complete mold removal services to help restore your health and peace of mind.
How do you tell if you have mold poisoning? Common signs include chronic fatigue, respiratory issues, brain fog, headaches, and skin irritation. If symptoms improve when you leave your home, it may be mold-related.
How can I check myself for mold toxicity? While no at-home test is definitive, some functional medicine providers offer urine mycotoxin testing. The most effective approach is a combination of medical evaluation and a professional home inspection.
How to detox mold from the body? Detoxing may involve binding agents like activated charcoal, dietary changes, and liver support—always under medical supervision. More importantly, removing the source of mold exposure is critical to healing.
Can mold sickness be reversed? Yes, many people recover fully once mold exposure is eliminated and their bodies are supported through recovery. Early action improves the chances of full reversal.
What should I do if I think I have mold toxicity? Schedule a mold inspection with a certified remediation company. Avoid DIY removal, which can worsen exposure.

Your home should be a safe and healthy place to live. If you suspect mold might be affecting your health, contact Rehab Restoration today. Our team is ready to assess the problem and provide expert mold remediation to help you breathe easier again.
Call now or schedule your inspection online.
Serving Greenville, Spartanburg, Anderson, and the entire Upstate South Carolina region.